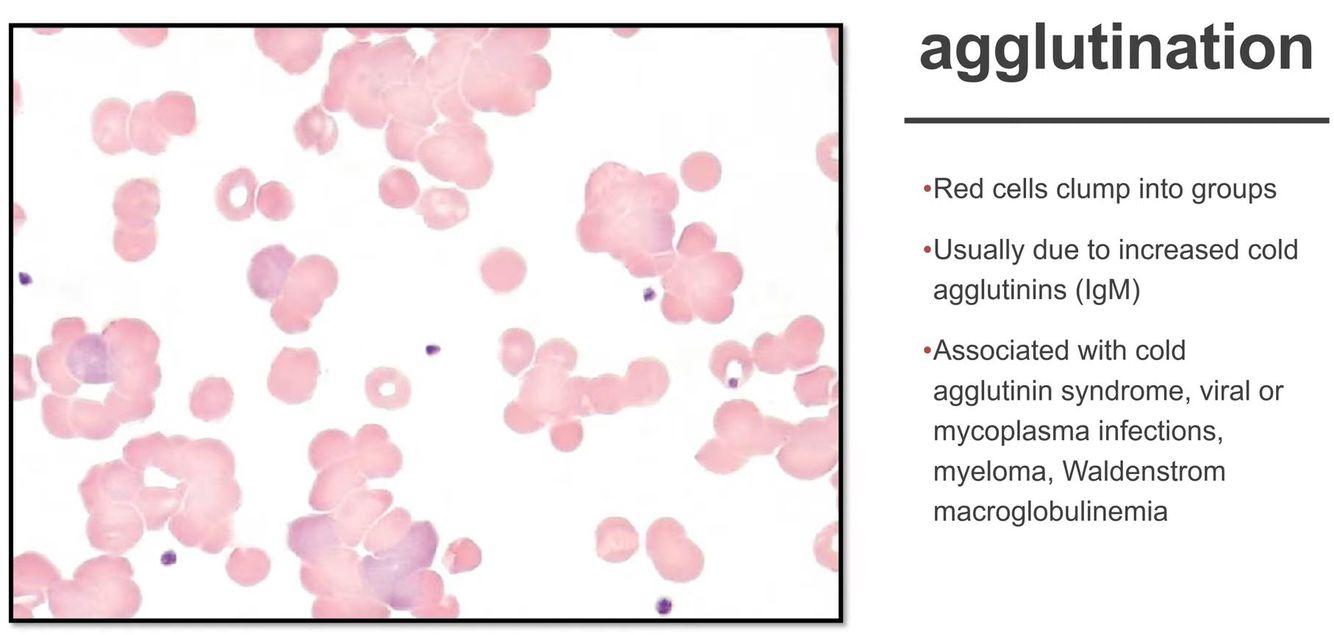
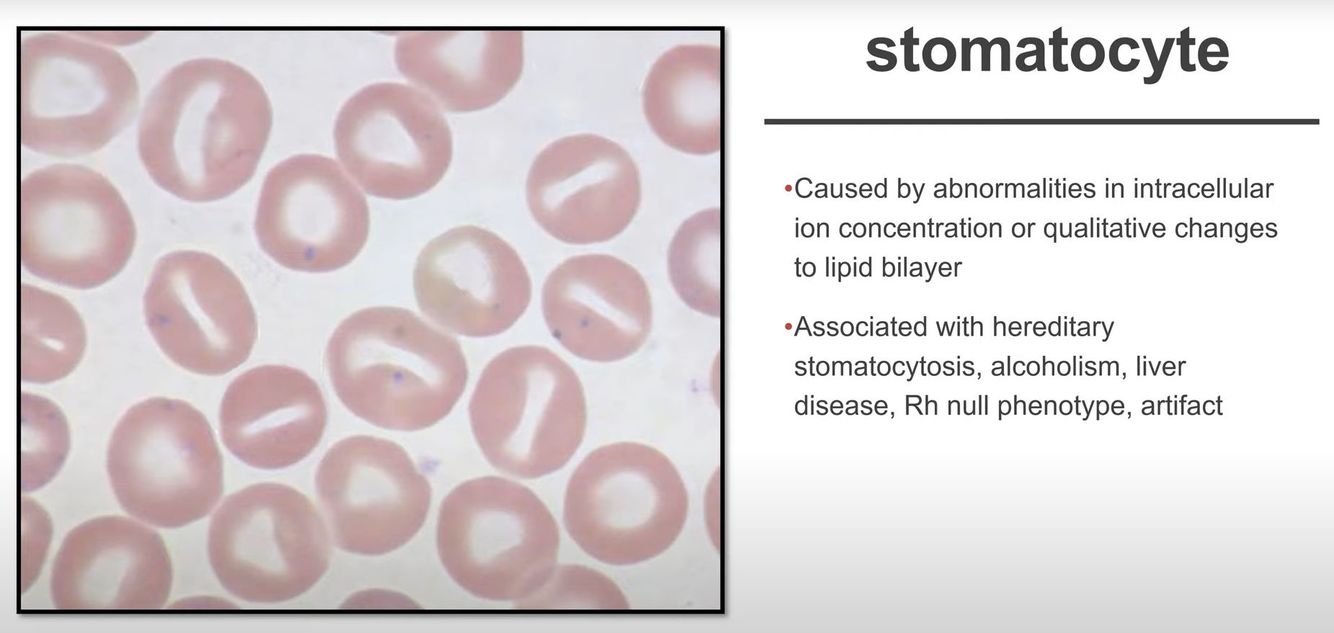
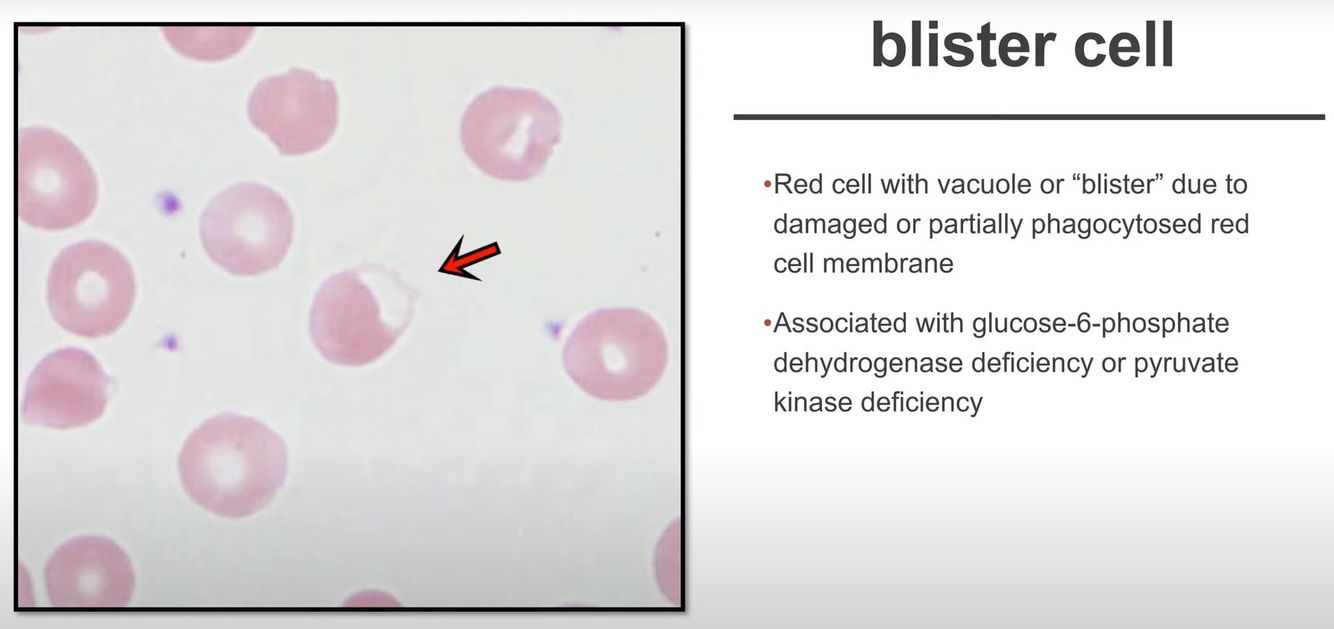
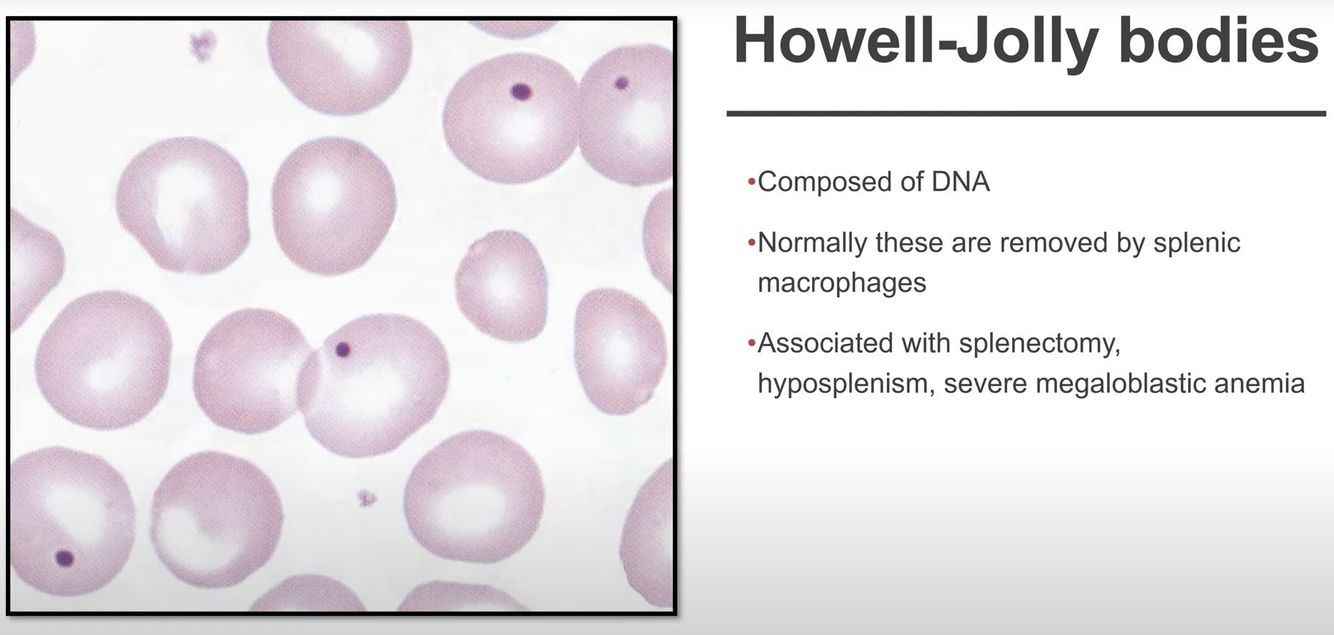
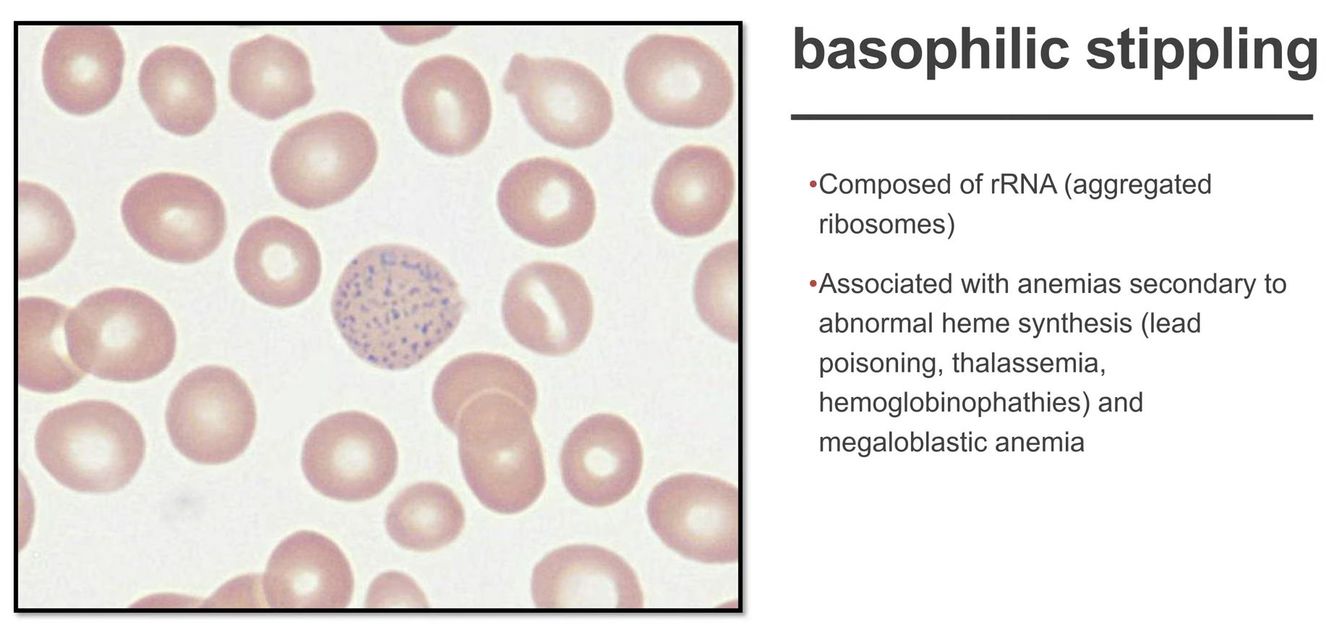
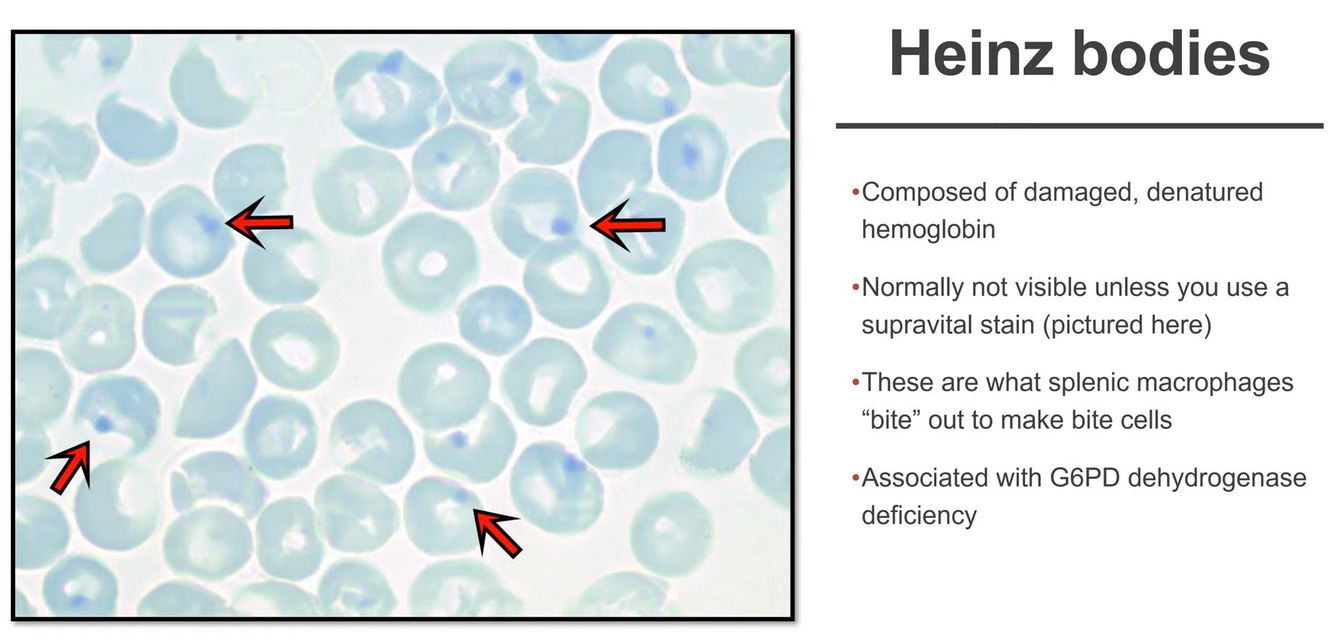
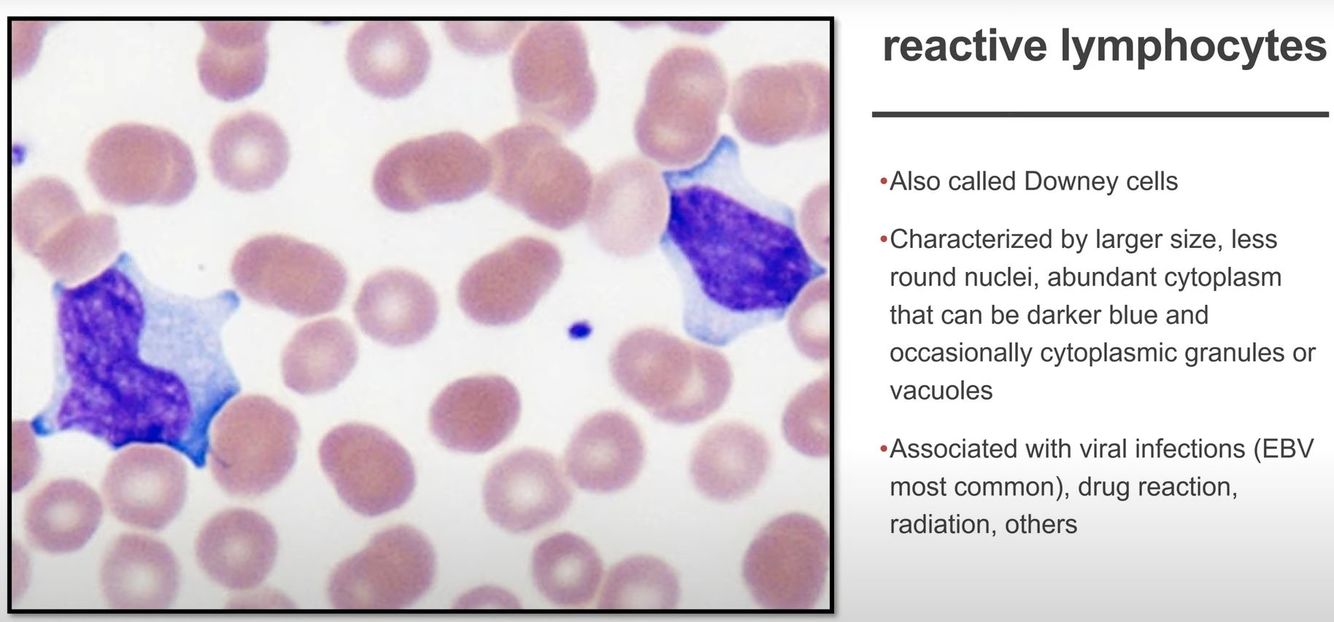
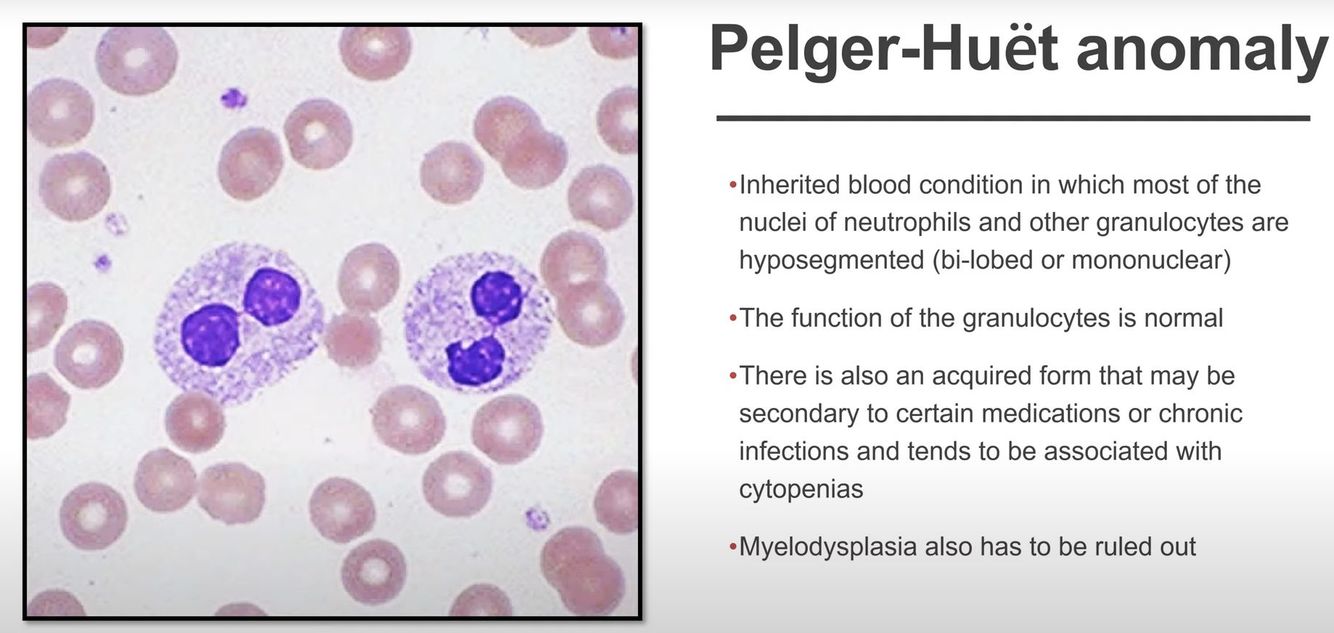
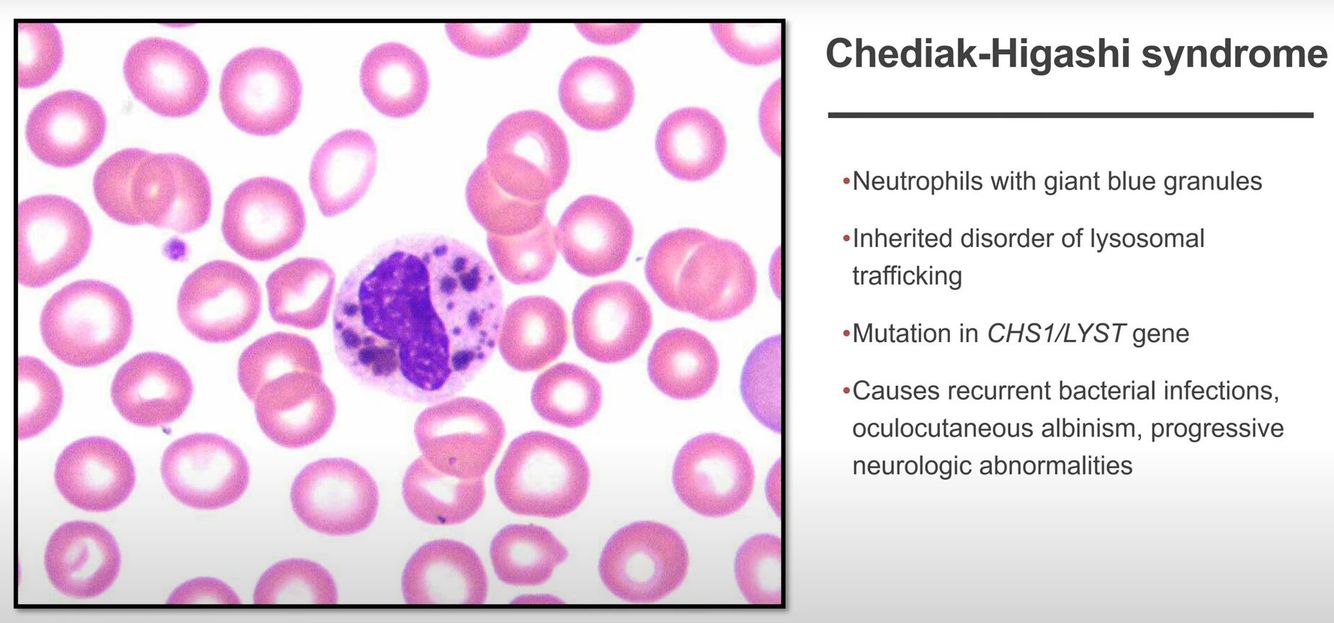

Differential for non-megaloblastic macrocytosis
- Liver disease
- Reticulocytosis (due to retics)
- Myelodysplastic syndrome
What does a finding of rouleaux on hematopathology represent?
High concentration of protein, usually fibrinogen or immunoglobulins
However! There is always rouleaux on the location a drop of blood is placed on the slide initially. So, make sure you look at the whole slide before calling rouleaux.
Agglutination
Stomatocytes
Acanthocytes

Echinocytes

When you see dacryocytes, you need to check. . .
. . . if they are all facing the same direction
If so, it is likely an artifact
Blister cells
Hemoglobin C disease

Hb SC disease

Howell-Jolly bodies
Pappenheimer bodies

Basophilic stippling
Heinz bodies
Note: These are usually visualized with a methylene blue stain
Cabot ring

Ways to differentiate babesia from malaria
- Maltese cross formation is always babesia
- Babesia will have mostly rings and rarely maltese crosses, but no other intracellular forms – malaria can take a few shapes
- Babesia may live extracellularly, so you may catch some parasites outside red cells. Malaria is obligate intracellular.
- Travel history! Babesia is common in the US and some parts of Europe. Malaria is across tropical areas, but especially tropical Africa and Asia
Active CD8+ T cells
Toxic granulation

Dohle bodies

Alder-Reilly anomaly

Pelger Huet anomaly
- “Dumbell neutrophils”
- Acquired form is “pseudo-Pelger-Huet”, which may be in association with myelodysplasia
Chediak Higashi syndrome
Visualization of these cells on the smear is diagnostic of the condition
Histoplasmosis

Anaplasmosis / Ehrlichosis
Note: Usually only present during the first week of infection



























